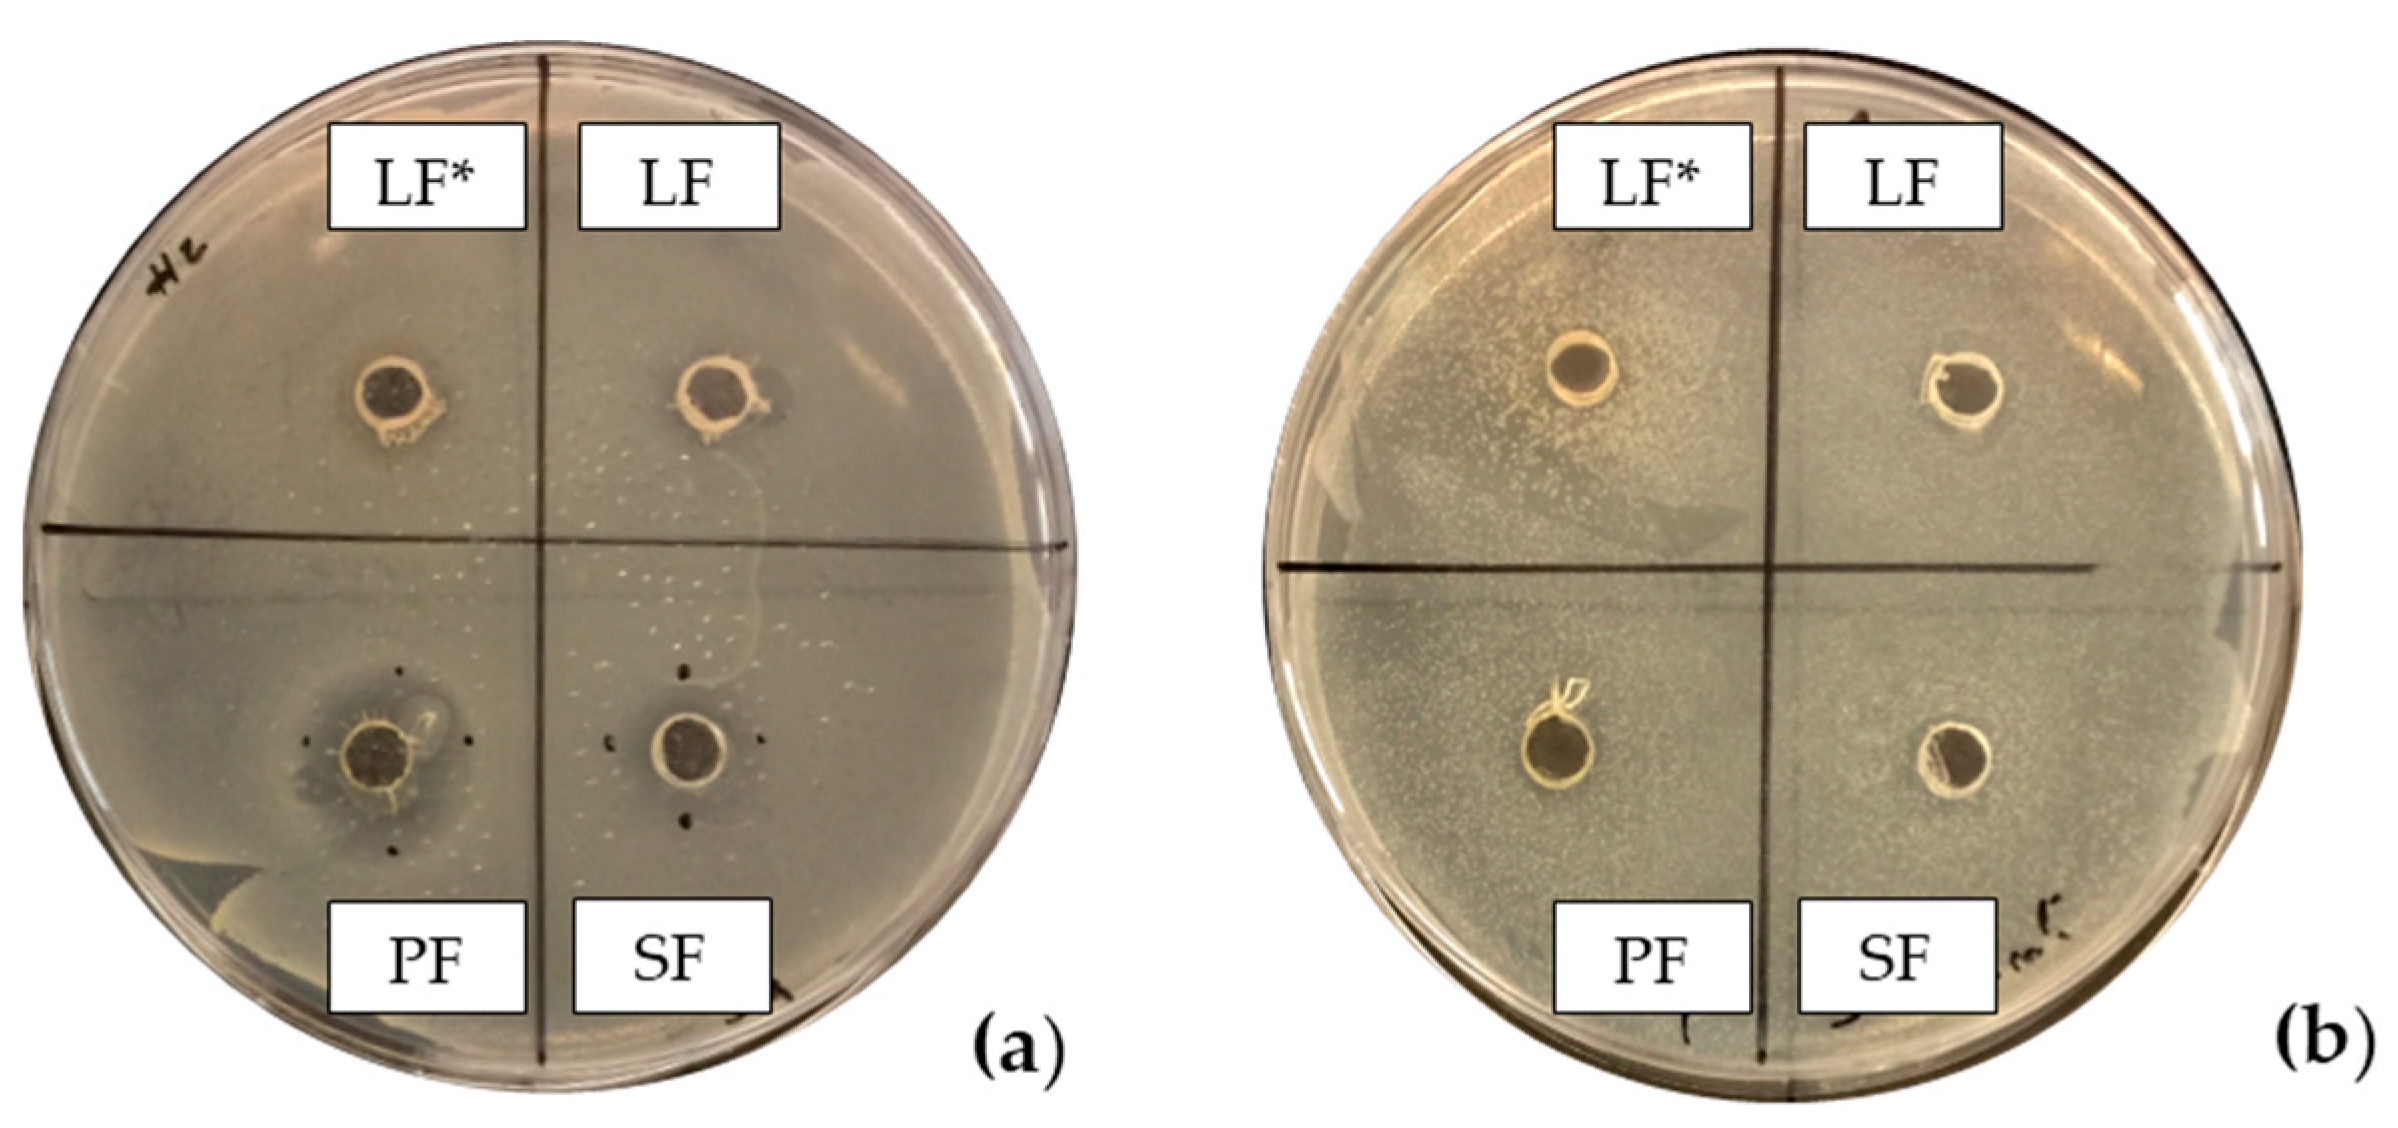
Antibiotics 13 00932 g001

Antimicrobial Properties of Fennel By-Product Extracts and Their Potential Applications in Meat Products
Abstract
1. Introduction
2. Results and Discussion
2.1. Total Phenolic and HPLC Analyses of the Phenolic Compounds in the Fennel Extracts
2.2. Antioxidant Activity of the Fennel Extracts
2.3. Antimicrobial Screening of Fennel Fraction Extracts
2.4. Effects of Selected Fennel Extract on Beef Burgers
Microbiological Analysis
3. Materials and Methods
3.1. Reagents and Standards
3.2. Preparation of Vegetable Extracts
3.3. Total Phenolic Content (TPC)
3.4. Analysis of Phenolic Compounds Using HPLC
3.5. Antioxidant Activity of Fennel Fraction Extracts
3.6. Antimicrobial Screening of Fennel Fraction Extracts
3.6.1. Inoculum Preparation
3.6.2. Agar-Well Diffusion Assay
3.6.3. Microplate-Based Assay
3.7. Evaluation of Effects of Selected Fennel Extracts on Beef Burgers
3.7.1. Beef Burger Processing and Analyses
3.7.2. Microbiological and Chemical Analysis
3.8. Statistical Analysis
4. Conclusions
5. Patents
Author Contributions
Funding
Institutional Review Board Statement
Informed Consent Statement
Data Availability Statement
Acknowledgments
Conflicts of Interest
References
- Meinilä, J.; Virtanen, J.K. Meat and Meat Products—A Scoping Review for Nordic Nutrition Recommendations 2023. Food Nutr. Res. 2024, 68, 333–342. [Google Scholar] [CrossRef] [PubMed]
- Morsy, M.K.; Elsabagh, R. Quality Parameters and Oxidative Stability of Functional Beef Burgers Fortified with Microencapsulated Cod Liver Oil. LWT-Food Sci. Technol. 2021, 142, 110959. [Google Scholar] [CrossRef]
- Abril, M.; Campo, M.; Onenc, A.; Sanudo, C.; Albertì, P.; Negueruela, A. Beef Colour Evolution as a Function of Ultimate PH. Meat Sci. 2001, 58, 69–78. [Google Scholar] [CrossRef] [PubMed]
- Bantawa, K.; Rai, K.; Subba Limbu, D.; Khanal, H. Food-Borne Bacterial Pathogens in Marketed Raw Meat of Dharan, Eastern Nepal. BMC Res. Notes 2018, 11, 618. [Google Scholar] [CrossRef]
- Del Nobile, M.A.; Conte, A.; Cannarsi, M.; Sinigaglia, M. Strategies for Prolonging the Shelf Life of Minced Beef Patties. J. Food Saf. 2009, 29, 14–25. [Google Scholar] [CrossRef]
- Bhandare, S.G.; Sherikar, A.T.; Paturkar, A.M.; Waskar, V.S.; Zende, R.J. A Comparison of Microbial Contamination on Sheep/Goat Carcasses in a Modern Indian Abattoir and Traditional Meat Shops. Food Control 2007, 18, 854–858. [Google Scholar] [CrossRef]
- Addis, M. Major Causes Of Meat Spoilage and Preservation Techniques: A Review. Food Sci. Qual. Manag. 2015, 41, 106–110. [Google Scholar]
- Shahbazi, Y.; Shavisi, N.; Mohebi, E. Effects of Ziziphora Clinopodioides Essential Oil and Nisin, Both Separately and in Combination, to Extend Shelf Life and Control Escherichia ColiO157: H7 and Staphylococcus Aureus in Raw Beef Patty during Refrigerated Storage. J. Food Saf. 2016, 36, 227–236. [Google Scholar] [CrossRef]
- Regulation (EC). Regulation (EC) No 1333/2008 of the European Parliament and of the Council of 16 December 2008 on Food Additives. Off. J. Eur. Union 2008, L354, 16–33. [Google Scholar]
- Zhang, Y.; Zhang, Y.; Jia, J.; Peng, H.; Qian, Q.; Pan, Z.; Liu, D. Nitrite and Nitrate in Meat Processing: Functions and Alternatives. Curr. Res. Food Sci. 2023, 6, 100470. [Google Scholar] [CrossRef]
- Costagliola, A.; Roperto, F.; Benedetto, D.; Anastasio, A.; Marrone, R.; Perillo, A.; Russo, V.; Papparella, S.; Paciello, O. Outbreak of Fatal Nitrate Toxicosis Associated with Consumption of Fennels (Foeniculum Vulgare) in Cattle Farmed in Campania Region (Southern Italy). Environ Sci Pollut R. 2014, 21, 6252–6257. [Google Scholar] [CrossRef] [PubMed]
- Nair, B. Food Science and Technology Final Report on the Safety Assessment of Benzyl Alcohol, Benzoic Acid, and Sodium Benzoate. Int. J. Toxicol. 2001, 20, 23–50. [Google Scholar] [PubMed]
- Honorato, T.C.; Batista, E.; de O. do Nascimento, K.; Pires, T. Food Additives: Applications and Toxicology. Rev. Verde De Agroecol. E Desenvolv. Sustentável 2013, 8, 1–11. [Google Scholar]
- Silva, M.M.; Lidon, F.C. Food Preservatives - An Overview on Applications and Side Effects. Emir. J. Food Agric. 2016, 28, 366–373. [Google Scholar] [CrossRef]
- Rangel Guimarães, R.; Cristina, M.; De Freitas, J.; Lucia, V.; Da Silva, M. Bolos Simples Elaborados Com Farinha Da Entrecasca de Melancia (Citrullus Vulgaris, Sobral): Avaliação Química, Fisica e Sensorial Simple Cakes Elaborated with Flour of Watermelon Inner Skin (Citrullus Vulgaris, Sobral): Chemical, Physical, and Sensory Evaluation. Ciênc. Tecnol. Aliment. 2010, 30, 354. [Google Scholar]
- Ramos, E.M.; de Miranda Gomide, L.A. Avaliação Da Qualidade de Carnes: Fundamentos e Metodologias, 1st ed.; Editora UFV: Viçosa, Brazil, 2007. [Google Scholar]
- Sales, P.V.G.; Sales, V.H.G.; Oliveira, E.M. Avaliação Sensorial de Duas Formulações de Hambúrguer de Peixe. Rev. Bras. De Prod. Agroindustriais 2015, 17, 17–23. [Google Scholar] [CrossRef]
- Varela, P.; Fiszman, S.M. Exploring Consumers’ Knowledge and Perceptions of Hydrocolloids Used as Food Additives and Ingredients. Food Hydrocoll. 2013, 30, 477–484. [Google Scholar] [CrossRef]
- Ge, H.; Fu, S.; Guo, H.; Hu, M.; Xu, Z.; Zhou, X.; Chen, X.; Jiao, X. Application and Challenge of Bacteriophage in the Food Protection. Int. J. Food Microbiol. 2022, 380, 109872. [Google Scholar] [CrossRef]
- Elois, M.A.; da Silva, R.; Pilati, G.V.T.; Rodríguez-Lázaro, D.; Fongaro, G. Bacteriophages as Biotechnological Tools. Viruses 2023, 15, 349. [Google Scholar] [CrossRef]
- Bhattacharya, D.; Nanda, P.K.; Pateiro, M.; Lorenzo, J.M.; Dhar, P.; Das, A.K. Lactic Acid Bacteria and Bacteriocins: Novel Biotechnological Approach for Biopreservation of Meat and Meat Products. Microorganisms 2022, 10, 2058. [Google Scholar] [CrossRef]
- Kalogianni, A.I.; Lazou, T.; Bossis, I.; Gelasakis, A.I. Natural Phenolic Compounds for the Control of Oxidation, Bacterial Spoilage, and Foodborne Pathogens in Meat. Foods 2020, 9, 794. [Google Scholar] [CrossRef] [PubMed]
- Yu, H.H.; Chin, Y.W.; Paik, H.D. Application of Natural Preservatives for Meat and Meat Products against Food-borne Pathogens and Spoilage Bacteria: A Review. Foods 2021, 10, 2418. [Google Scholar] [CrossRef] [PubMed]
- Danilović, B.; Đorđević, N.; Milićević, B.; Šojić, B.; Pavlić, B.; Tomović, V.; Savić, D. Application of Sage Herbal Dust Essential Oils and Supercritical Fluid Extract for the Growth Control of Escherichia Coli in Minced Pork during Storage. LWT-Food Sci. Technol. 2021, 141, 110935. [Google Scholar] [CrossRef]
- de Alencar, M.G.; de Quadros, C.P.; Luna, A.L.L.P.; Neto, A.F.; da Costa, M.M.; Queiroz, M.A.Á.; de Carvalho, F.A.L.; da Silva Araújo, D.H.; Gois, G.C.; dos Anjos Santos, V.L.; et al. Grape Skin Flour Obtained from Wine Processing as an Antioxidant in Beef Burgers. Meat Sci. 2022, 194, 108963. [Google Scholar] [CrossRef]
- Elhadef, K.; Smaoui, S.; Ben Hlima, H.; Ennouri, K.; Fourati, M.; Chakchouk Mtibaa, A.; Ennouri, M.; Mellouli, L. Effects of Ephedra Alata Extract on the Quality of Minced Beef Meat during Refrigerated Storage: A Chemometric Approach. Meat Sci. 2020, 170, 108246. [Google Scholar] [CrossRef]
- Kalleli, F.; Bettaieb Rebey, I.; Wannes, W.A.; Boughalleb, F.; Hammami, M.; Saidani Tounsi, M.; M’hamdi, M. Chemical Composition and Antioxidant Potential of Essential Oil and Methanol Extract from Tunisian and French Fennel (Foeniculum Vulgare Mill.) Seeds. J. Food Biochem. 2019, 43, e12935. [Google Scholar] [CrossRef]
- Noreen, S.; Rehman, H.U.; Tufail, T.; Badar Ul Ain, H.; Awuchi, C.G. Secoisolariciresinol Diglucoside and Anethole Ameliorate Lipid Abnormalities, Oxidative Injury, Hypercholesterolemia, Heart, and Liver Conditions. Food Sci. Nutr. 2023, 11, 2620–2630. [Google Scholar] [CrossRef]
- Saddiqi H., A.; Iqbal, Z. Chapter 55—Usage and Significance of Fennel (Foeniculum Vulgare Mill.) Seeds in Eastern Medicine; Elsevier: Amsterdam, The Netherlands,, 2011; pp. 461–467. [Google Scholar]
- Barros, L.; Carvalho, A.M.; Ferreira, I.C.F.R. The Nutritional Composition of Fennel (Foeniculum Vulgare): Shoots, Leaves, Stems and Inflorescences. LWT-Food Sci. Technol. 2010, 43, 814–818. [Google Scholar] [CrossRef]
- Badgujar, S.B.; Patel, V.V.; Bandivdekar, A.H. Foeniculum vulgare Mill: A Review of Its Botany, Phytochemistry, Pharmacology, Contemporary Application, and Toxicology. Biomed. Res. Int. 2014, 2014, 842674. [Google Scholar] [CrossRef]
- Choi, E.M.; Hwang, J.K. Antiinflammatory, Analgesic and Antioxidant Activities of the Fruit of Foeniculum Vulgare. Fitoterapia 2004, 75, 557–565. [Google Scholar] [CrossRef]
- Agarwal Scholar, D.; Agarwal, D.; Sharma, L.; Saxena, S. Anti-Microbial Properties of Fennel (Foeniculum vulgare Mill.) Seed Extract. J. Pharmacogn. Phytochem. 2017, 6, 479–482. [Google Scholar]
- Abdellaoui, M.; Derouich, M.; El-Rhaffari, L. Essential Oil and Chemical Composition of Wild and Cultivated Fennel (Foeniculum Vulgare Mill.): A Comparative Study. S. Afr. J. Bot. 2020, 135, 93–100. [Google Scholar] [CrossRef]
- Diao, W.R.; Hu, Q.P.; Zhang, H.; Xu, J.G. Chemical Composition, Antibacterial Activity and Mechanism of Action of Essential Oil from Seeds of Fennel (Foeniculum vulgare Mill.). Food Control 2014, 35, 109–116. [Google Scholar] [CrossRef]
- Sun, Y.; Zhang, M.; Bhandari, B.; Bai, B. Fennel Essential Oil Loaded Porous Starch-Based Microencapsulation as an Efficient Delivery System for the Quality Improvement of Ground Pork. Int. J. Biol. Macromol. 2021, 172, 464–474. [Google Scholar] [CrossRef] [PubMed]
- Gómez-García, R.; Campos, D.A.; Aguilar, C.N.; Madureira, A.R.; Pintado, M. Valorisation of Food Agro-Industrial by-Products: From the Past to the Present and Perspectives. J. Environ. Manag. 2021, 299, 113571. [Google Scholar] [CrossRef] [PubMed]
- Roby, M.H.H.; Sarhan, M.A.; Selim, K.A.H.; Khalel, K.I. Antioxidant and Antimicrobial Activities of Essential Oil and Extracts of Fennel (Foeniculum vulgare L.) and Chamomile (Matricaria chamomilla L.). Ind. Crops Prod. 2013, 44, 437–445. [Google Scholar] [CrossRef]
- Salami, M.; Rahimmalek, M.; Ehtemam, M.H. Inhibitory Effect of Different Fennel (Foeniculum Vulgare) Samples and Their Phenolic Compounds on Formation of Advanced Glycation Products and Comparison of Antimicrobial and Antioxidant Activities. Food Chem. 2016, 213, 196–205. [Google Scholar] [CrossRef]
- Ahmed, A.F.; Shi, M.; Liu, C.; Kang, W. Comparative Analysis of Antioxidant Activities of Essential Oils and Extracts of Fennel (Foeniculum Vulgare Mill.)Seeds from Egypt and China. Food Science and Human Wellness 2019, 8, 67–72. [Google Scholar] [CrossRef]
- Tlili, N.; Elfalleh, W.; Hannachi, H.; Yahia, Y.; Khaldi, A.; Ferchichi, A.; Nasri, N. Screening of Natural Antioxidants from Selected Medicinal Plants. Int J Food Prop 2013, 16, 1117–1126. [Google Scholar] [CrossRef]
- Oktay, M.; Gülçin, I.; Küfrevioǧlu, Ö.I. Determination of in Vitro Antioxidant Activity of Fennel (Foeniculum Vulgare) Seed Extracts. LWT 2003, 36, 263–271. [Google Scholar] [CrossRef]
- Ghasemian, A.; Al-Marzoqi, A.H.; Mostafavi, S.K.S.; Alghanimi, Y.K.; Teimouri, M. Chemical Composition and Antimicrobial and Cytotoxic Activities of Foeniculum Vulgare Mill Essential Oils. J. Gastrointest. Cancer 2020, 51, 260–266. [Google Scholar] [CrossRef] [PubMed]
- Barrahi, M.; Esmail, A.; Elhartiti, H.; Chahboun, N.; Benali, A.; Amiyare, R.; Lakhrissi, B.; Rhaiem, N.; Zarrouk, A.; Ouhssine, M. Chemical Composition and Evaluation of Antibacterial Activity of Fennel (Foeniculum Vulgare Mill) Seed Essential Oil against Some Pathogenic Bacterial Strains. Casp. J. Environ. Sci. 2020, 18, 295–307. [Google Scholar] [CrossRef]
- Lemiasheuski, V.; Ji, Y.; Buchenkov, I.; Gritskevitch, E.; Sysa, A. Evaluation of the Antibacterial Effect of Foeniculum Vulgare Mill. Essential Oil on Opportunistic Microflora: Growth and Enzymatic Activity Indicators. Asian J. Res. Biochem. 2024, 14, 138–148. [Google Scholar] [CrossRef]
- Ghafarizadeh, A.; Seyyednejad, S.M.; Motamedi, H.; Shahbazi, F. Evaluation of the antibacterial activity of different parts of Foeniculum vulgare (fennel) extracts. J. Med. Herbs 2018, 9, 33–38. [Google Scholar]
- Rafieian, F.; Amani, R.; Rezaei, A.; Karaça, A.C.; Jafari, S.M. Exploring Fennel (Foeniculum vulgare): Composition, Functional Properties, Potential Health Benefits, and Safety. Crit. Rev. Food Sci. Nutr. 2024, 64, 6924–6941. [Google Scholar] [CrossRef]
- Elbaz, M.; Abdesslem, S.B.; St-Gelais, A.; Boulares, M.; Moussa, O.B.; Timoumi, M.; Hassouna, M.; Aider, M. Essential Oils Profile, Antioxidant and Antibacterial Potency of Tunisian Fennel (Foeniculum vulgare Mill.) Leaves Grown under Conventional and Organic Conditions. Food Chem. Adv. 2024, 4, 100734. [Google Scholar] [CrossRef]
- Joshi, R.K. Chemical Constituents and Antibacterial Property of the Essential Oil of the Roots of Cyathocline Purpurea. J. Ethnopharmacol. 2013, 145, 621–625. [Google Scholar] [CrossRef]
- Shakeri, A.; Khakdan, F.; Soheili, V.; Sahebkar, A.; Rassam, G.; Asili, J. Chemical Composition, Antibacterial Activity, and Cytotoxicity of Essential oil from Nepeta ucrainica L. Spp. Kopetdaghensis. Ind. Crops Prod. 2014, 58, 315–321. [Google Scholar] [CrossRef]
- Di Napoli, M.; Castagliuolo, G.; Badalamenti, N.; Maresca, V.; Basile, A.; Bruno, M.; Varcamonti, M.; Zanfardino, A. Antimicrobial, Antibiofilm, and Antioxidant Properties of Essential Oil of Foeniculum Vulgare Mill. Leaves. Plants 2022, 11, 3573. [Google Scholar] [CrossRef]
- Lo Cantore, P.; Iacobellis, N.S.; De Marco, A.; Capasso, F.; Senatore, F. Antibacterial Activity of Coriandrum sativum L. and Foeniculum vulgare Miller Var. vulgare (Miller) Essential Oils. J. Agric. Food Chem. 2004, 52, 7862–7866. [Google Scholar] [CrossRef]
- Chiboub, W.; Sassi, A.B.; Amina, C.M.H.; Souilem, F.; El Ayeb, A.; Djlassi, B.; Ascrizzi, R.; Flamini, G.; Harzallah-Skhiri, F. Valorization of the Green Waste from Two Varieties of Fennel and Carrot Cultivated in Tunisia by Identification of the Phytochemical Profile and Evaluation of the Antimicrobial Activities of Their Essentials Oils. Chem. Biodivers. 2019, 16, e1800546. [Google Scholar] [CrossRef] [PubMed]
- Özcan, M.M.; Saǧdıç, O.; Özkan, G. Short Communication Inhibitory Effects of Spice Essential Oils on the Growth of Bacillus Species. J. Med. Food 2006, 9, 418–421. [Google Scholar] [CrossRef] [PubMed]
- Górniak, I.; Bartoszewski, R.; Króliczewski, J. Comprehensive Review of Antimicrobial Activities of Plant Flavonoids. Phytochem. Rev. 2019, 18, 241–272. [Google Scholar] [CrossRef]
- Berthold-Pluta, A.; Stasiak-Różańska, L.; Pluta, A.; Garbowska, M. Antibacterial Activities of Plant-Derived Compounds and Essential Oils against Cronobacter Strains. Eur. Food Res. Technol. 2019, 245, 1137–1147. [Google Scholar] [CrossRef]
- Almuzaini, A.M. Phytochemicals: Potential Alternative Strategy to Fight Salmonella Enterica Serovar Typhimurium. Front. Vet. Sci. 2023, 10, 1188752. [Google Scholar] [CrossRef]
- Shabnam, J.; Sobia, M.; Ibatsam, K.; Rauf, A.; M, S.H. Comparative Antimicrobial Activity of Clove and Fennel Essential Oils against Food Borne Pathogenic Fungi and Food Spoilage Bacteria. Afr. J. Biotechnol. 2012, 11, 16065–16070. [Google Scholar] [CrossRef]
- Manonmani, R.; Khadir, V.A. Khadir Antibacterial Screening on Foeniculum Vulgare Mill. Int. J. Pharma Bio Sci. 2011, 2, 390–394. [Google Scholar]
- Gheorghita, D.; Robu, A.; Antoniac, A.; Antoniac, I.; Ditu, L.M.; Raiciu, A.D.; Tomescu, J.; Grosu, E.; Saceleanu, A. In Vitro Antibacterial Activity of Some Plant Essential Oils against Four Different Microbial Strains. Appl. Sci. 2022, 12, 9482. [Google Scholar] [CrossRef]
- Yi, Q.; Zhang, J.; Ai, D. Antimicrobial Effects of Essential Oils on Pseudomonas Aeruginosa. J. Pathol. Res. Rev. Rep. 2022, 152, 2–6. [Google Scholar] [CrossRef]
- Shahat, A.A.; Ibrahim, A.Y.; Hendawy, S.F.; Omer, E.A.; Hammouda, F.M.; Abdel-Rahman, F.H.; Saleh, M.A. Chemical Composition, Antimicrobial and Antioxidant Activities of Essential Oils from Organically Cultivated Fennel Cultivars. Molecules 2011, 16, 1366–1377. [Google Scholar] [CrossRef]
- Commission Regulation (EC) Commission Regulation (EC) No 1441/2007 of 5 December 2007 Amending Regulation (EC) No 2073/2005 on Microbiological Criteria for Foodstuffs. Off. J. Eur. Communities 2007, L322.
- Mujović, M.; Šojić, B.; Danilović, B.; Kocić-Tanackov, S.; Ikonić, P.; Đurović, S.; Milošević, S.; Bulut, S.; Đorđević, N.; Savanović, J.; et al. Fennel (Foeniculum Vulgare) Essential Oil and Supercritical Fluid Extracts as Novel Antioxidants and Antimicrobial Agents in Beef Burger Processing. Food Biosci. 2023, 56, 103283. [Google Scholar] [CrossRef]
- Saleh, S.M.; Kassab H., A.; Mariam, A.R.; El-Bana M., A. Fennel and Turmeric Powders’ Effectiveness as Natural in Beef Burgers. Rom. Biotechnol. Lett. 2022, 27, 3186–3192. [Google Scholar] [CrossRef]
- Kim, J.S.; Kwon, Y.S.; Chun, W.J.; Kim, T.Y.; Sun, J.; Yu, C.Y.; Kim, M.J. Rhus Verniciflua Stokes Flavonoid Extracts Have Anti-Oxidant, Anti-Microbial and α-Glucosidase Inhibitory Effect. Food Chem. 2010, 120, 539–543. [Google Scholar] [CrossRef]
- Huang, L.; Wang, Y.; Li, R.; Wang, Q.; Dong, J.; Wang, J.; Lu, S. Thyme Essential Oil and Sausage Diameter Effects on Biogenic Amine Formation and Microbiological Load in Smoked Horse Meat Sausage. Food Biosci. 2021, 40, 100885. [Google Scholar] [CrossRef]
- Gómez-García, R.; Campos, D.A.; Oliveira, A.; Aguilar, C.N.; Madureira, A.R.; Pintado, M. A Chemical Valorisation of Melon Peels towards Functional Food Ingredients: Bioactives Profile and Antioxidant Properties. Food Chem. 2021, 335, 127579. [Google Scholar] [CrossRef]
- Campos, D.A.; Ribeiro, T.B.; Teixeira, J.A.; Pastrana, L.; Pintado, M.M. Integral Valorization of Pineapple (Ananas Comosus L.) By-Products through a Green Chemistry Approach towards Added Value Ingredients. Foods 2020, 9, 60. [Google Scholar] [CrossRef]
- ISO 4833-1:2013; Microbiology of the Food Chain: Horizontal Method for the Enumeration of Microorganisms—Part 1: Colony Count at 30 °C by the Pour Plate Technique. International Organization for Standardization: Geneva, Switzerland, 2013.
- Roshanak, S.; Shahidi, F.; Yazdi, F.T.; Javadmanesh, A.; Movaffagh, J. Evaluation of Antimicrobial Activity of Buforin I and Nisin and the Synergistic Effect of Their Combination as a Novel Antimicrobial Preservative. J. Food Prot. 2020, 83, 2018–2025. [Google Scholar] [CrossRef]
- Pla, M.L.; Oltra, S.; Esteban, M.D.; Andreu, S.; Palop, A. Comparison of Primary Models to Predict Microbial Growth by the Plate Count and Absorbance Methods. Biomed. Res. Int. 2015, 2015, 365025. [Google Scholar] [CrossRef]
- ISO 4831:2006; Microbiology of Food and Animal Feeding STUFFS—Horizontal Method for the Detection and Enumeration of Coliforms—Most Probable Number Technique. International Organization for Standardization: Geneva, Switzerland, 2006.
- ISO 16649-2:2001; Microbiology of Food and Animal Feeding Stuffs Horizontal Method for the Enumeration of Beta-Glucuronidase-Positive Escherichia Coli Part 2: Colony-Count Technique at 44 Degrees C Using 5-Bromo-4-Chloro-3-Indolyl Beta-D-Glucuronide. International Organization for Standardization: Geneva, Switzerland, 2001.
- ISO 6888-1999; Microbiology of Food and Animal Feeding Stuffs—Horizontal Method for Enumeration of Coagulase-Positive Staphylococci (Staphylococcus aureus and Other Species)—Part 1: Technique Using Baird-Parker Agar. ISO: Geneva, Switzerland, 1999; pp. 1–11.
- ISO 21527-2:2008; Microbiology of Food and Animal Feeding Stuffs-Horizontal Method for the Enumeration of Yeast and Moulds-Part 2: Colony Count Technique in Products with Water Activity Less than or Equal to 0.95. International Organization for Standardization: Geneva, Switzerland, 2008.
- ISO 11290-1:2017; Microbiology of the Food Chain Horizontal Method for the Detection and Enumeration of Listeria Monocytogenes and of Listeria spp. Part 1: Detection Method. International Organization for Standardization: Geneva, Switzerland, 2017.
- ISO 6579-1:2017; Microbiology of the Food Chain–Horizontal Method for the Detection, Enumeration and Serotyping of Salmonella-Part 1: Detection of Salmonella spp. International Organization for Standardization: Geneva, Switzerland, 2017.
| Compound | Chemical Class | RT | Concentration (mg/100 g DE) | |||
|---|---|---|---|---|---|---|
| SF | LF | PF | ||||
| 1 | Gallic acid | Hydroxybenzoic acid | 14.07 | 22.45 ± 3.66 | 30.63 ± 1.58 | 30.05 ± 1.14 |
| 2 | 3,4 dihydroxybenzoic acid | Hydroxybenzoic acid | 17.49 | 42.88 ± 10.90 | 24.17 ± 1.24 | nd |
| 3 | Protocatechuic acid | Hydroxybenzoic acid | 17.92 | 83.86 ± 36.54 | 32.11 ± 1.92 | 126.89 ± 7.56 |
| 4 | Catechin | Flavonol | 23.53 | 10.38 ± 3.62 | 27.34 ± 1.57 | 79.54 ± 4.58 |
| 5 | Neochlorogenic acid | Hydroxycinnamic acids | 25.57 | ud | ud | ud |
| 6 | Chlorogenic acid | Hydroxycinnamic acids | 28.00 | ud | ud | ud |
| 7 | Dihydroxycaffeic acid | Hydroxycinnamic acids | 29.29 | 45.98 ± 6.76 | 27.43 ± 1.39 | 79.80 ± 4.05 |
| 8 | 4-Hydroxybenzoic acid | Hydroxybenzoic acid | 34.03 | nd | 90.90 ± 5.15 | 87.17 ± 4.58 |
| 9 | Caffeic acid | Hydroxycinnamic acids | 37.19 | 40.16 ± 0.30 | 9.53 ± 0.60 | 33.18 ± 2.05 |
| 10 | p-Coumaric | Hydroxybenzoic acid | 43.80 | 38.2 ± 6.41 | 36.35 ± 2.27 | 56.71 ± 3.37 |
| 11 | Ferulic acid | Hydroxybenzoic acid | 48.63 | ud | 22.81 ± 1.12 | 26.13 ± 0.90 |
| 12 | Myricetin | Flavonoid | 50.53 | ud | nd | ud |
| 13 | Naringinin-7-glucoside | Flavones | 52.45 | ud | ud | ud |
| 14 | Naringinin | Flavones | 53.45 | ud | ud | ud |
| 15 | Rutin | Flavonoid | 54.66 | 15.28 ± 12.51 | 2.09 ± 0.15 | 6.08 ± 0.45 |
| 16 | Quercetin | Flavonol | 55.13 | ud | ud | ud |
| 17 | Luteolin | Flovones | 56.46 | ud | ud | ud |
| Total by HPLC | 298.69 ± 24.16 | 303.37 ± 17.00 | 525.25 ± 29.05 | |||
| TPC (mg GAE/100 g DE) | 346.72 ± 17.67 | 369.49 ± 12.76 | 949.29 ± 114.37 | |||
| Antioxidant activity | ||||||
| ABTS (mg AAE/100 g DE) | 323.10 ± 25.11 | 328.85 ± 14.92 | 383.00 ± 18.07 | |||
| DPPH (μM TE/100 g DE) | 653.22 ± 14.66 | 143.64 ± 35.17 | 638.28 ± 46.70 | |||
| Fennel Extract | Positive Effect (×) | Concentration (mg DE/mL) | Inhibition Zone Diameter | |
|---|---|---|---|---|
| S. aureus | E. coli | (mm) | ||
| LF | - | - | 38.7 | - |
| LF* | - | - | 160 | - |
| SF | × | - | 110 | 10.00 ± 0.21 |
| PF | × | - | 20 | 10.50 ± 0.52 |
| Indicator Strains | SF | PF |
|---|---|---|
| Salmonella enterica serotype Enteritidis | ![]() | ![]() |
| Escherichia coli | ![]() | ![]() |
| Pseudomonas aeruginosa | ![]() | ![]() |
| Staphylococcus aureus | ![]() | ![]() |
| Bacillus cereus | ![]() | ![]() |
| Item | SF | PF | |||
|---|---|---|---|---|---|
| 50 mg DE/mL (5%) | 100 mg DE/mL (10%) | 150 mg DE/mL (15%) | 10 mg DE/mL (1%) | 20 mg DE/mL (2%) | |
| Absorbance | 0.843 | 0.556 | 0.271 | 1.013 | 0.300 |
| Inhibition index, % | 43.82 | 62.92 | 81.92 | 36.57 | 81.21 |
| Item | SF | PF | |||
|---|---|---|---|---|---|
| 50 mg DE/mL (5%) | 100 mg DE/mL (10%) | 150 mg DE/mL (15%) | 10 mg DE/mL (1%) | 20 mg DE/mL (2%) | |
| Absorbance | 1.199 | 0.717 | 0.253 | 1.013 | 0.300 |
| Inhibition index, % | 21.01 | 52.74 | 83.31 | 0.117 | 72.189 |
| Item | SF | PF | |||
|---|---|---|---|---|---|
| 50 mg DE/mL (5%) | 100 mg DE/mL (10%) | 150 mg DE/mL (15%) | 10 mg DE/mL (1%) | 20 mg DE/mL (2%) | |
| Absorbance | 0.820 | 0.475 | 0.253 | 0.956 | 0.291 |
| Inhibition index, % | 33.44 | 61.42 | 79.44 | 18.91 | 75.27 |
| Item | SF | PF | |||
|---|---|---|---|---|---|
| 50 mg DE/mL (5%) | 100 mg DE/mL (10%) | 150 mg DE/mL (15%) | 10 mg DE/mL (1%) | 20 mg DE/mL (2%) | |
| Absorbance | 0.298 | 0.240 | 0.242 | 1.027 | 0.266 |
| Inhibition index, % | 29.30 | 42.90 | 42.58 | - | 28.30 |
| Item | SF | PF | |||
|---|---|---|---|---|---|
| 50 mg DE/mL (5%) | 100 mg DE/mL (10%) | 150 mg DE/mL (15%) | 10 mg DE/mL (1%) | 20 mg DE/mL (2%) | |
| Absorbance | 0.266 | 0.236 | 0.274 | 0.498 | 0.236 |
| Inhibition index, % | 68.92 | 72.42 | 67.99 | 50.17 | 76.36 |
| Item | 0 d | 5 d | 8 d | 12 d | 15 d | 18 d | Limits | RE | |
|---|---|---|---|---|---|---|---|---|---|
| TAB 30 °C | TRT | 2.36 | 2.80 | 3.26 | 3.71 | 5.32 | 5.32 | m = 5.69 | Reg. CE 2073/05 s.m.i. 1441/07 |
| CTR | 2.43 | 2.84 | 3.34 | 3.81 | 5.50 | 5.52 | M = 6.69 | ||
| Total Coliforms | TRT | <1.0 | <1.0 | <1.0 | <1.0 | <1.0 | <1.0 | ||
| CTR | <1.0 | <1.0 | <1.0 | <1.0 | <1.0 | <1.0 | |||
| β-glucuronidase-positive Escherichia coli | TRT | <1.0 | <1.0 | <1.0 | <1.0 | <1.0 | <1.0 | m = 2.69 | Reg. CE 2073/05 s.m.i. 1441/07 |
| CTR | <1.0 | <1.0 | <1.0 | <1.0 | <1.0 | <1.0 | M = 3.69 | ||
| Yeasts and molds | TRT | <1.0 | <1.0 | <1.0 | <1.0 | 1.56 | 1.56 | ||
| CTR | <1.0 | <1.0 | 1.1 | 1.32 | 1.61 | 1.63 | |||
| Coagulase-positive Staphylococci | TRT | <1.0 | <1.0 | <1.0 | <1.0 | <1.0 | <1.0 | ||
| CTR | <1.0 | <1.0 | <1.0 | <1.0 | <1.0 | <1.0 | |||
| Listeria monocytogenes | TRT | <1.0 | <1.0 | <1.0 | <1.0 | <1.0 | <1.0 | 2.00 | Reg. CE 2073/05 s.m.i. 1441/07 |
| CTR | <1.0 | <1.0 | <1.0 | <1.0 | <1.0 | <1.0 | |||
| pH | TRT | 5.81 ± 0.02 | 5.70 ± 0.03 | 5.59 ± 0.02 | 5.48 ± 0.01 | 5.45 ± 0.01 | 5.40 ± 0.03 | ||
| CTR | 5.81 ± 0.02 | 5.73 ± 0.03 | 5.65 ± 0.02 | 5.53 ± 0.01 | 5.45 ± 0.02 | 5.37 ± 0.02 | |||
| aw | TRT | 0.979 ± 0.000 | 0.980 ± 0.002 | 0.981 ± 0.001 | 0.975 ± 0.006 | 0.976 ± 0.006 | 0.975 ± 0.004 | ||
| CTR | 0.979 ± 0.000 | 0.979 ± 0.001 | 0.980 ± 0.002 | 0.980 ± 0.000 | 0.975 ± 0.009 | 0.974 ± 0.003 |
Disclaimer/Publisher’s Note: The statements, opinions and data contained in all publications are solely those of the individual author(s) and contributor(s) and not of MDPI and/or the editor(s). MDPI and/or the editor(s) disclaim responsibility for any injury to people or property resulting from any ideas, methods, instructions or products referred to in the content. |
© 2024 by the authors. Licensee MDPI, Basel, Switzerland. This article is an open access article distributed under the terms and conditions of the Creative Commons Attribution (CC BY) license (https://creativecommons.org/licenses/by/4.0/).
Share and Cite
Egidio, M.; Casalino, L.; De Biasio, F.; Di Paolo, M.; Gómez-García, R.; Pintado, M.; Sardo, A.; Marrone, R. Antimicrobial Properties of Fennel By-Product Extracts and Their Potential Applications in Meat Products. Antibiotics 2024, 13, 932. https://doi.org/10.3390/antibiotics13100932
Egidio M, Casalino L, De Biasio F, Di Paolo M, Gómez-García R, Pintado M, Sardo A, Marrone R. Antimicrobial Properties of Fennel By-Product Extracts and Their Potential Applications in Meat Products. Antibiotics. 2024; 13(10):932. https://doi.org/10.3390/antibiotics13100932
Chicago/Turabian StyleEgidio, Marica, Loriana Casalino, Filomena De Biasio, Marika Di Paolo, Ricardo Gómez-García, Manuela Pintado, Alma Sardo, and Raffaele Marrone. 2024. "Antimicrobial Properties of Fennel By-Product Extracts and Their Potential Applications in Meat Products" Antibiotics 13, no. 10: 932. https://doi.org/10.3390/antibiotics13100932
APA StyleEgidio, M., Casalino, L., De Biasio, F., Di Paolo, M., Gómez-García, R., Pintado, M., Sardo, A., & Marrone, R. (2024). Antimicrobial Properties of Fennel By-Product Extracts and Their Potential Applications in Meat Products. Antibiotics, 13(10), 932. https://doi.org/10.3390/antibiotics13100932











